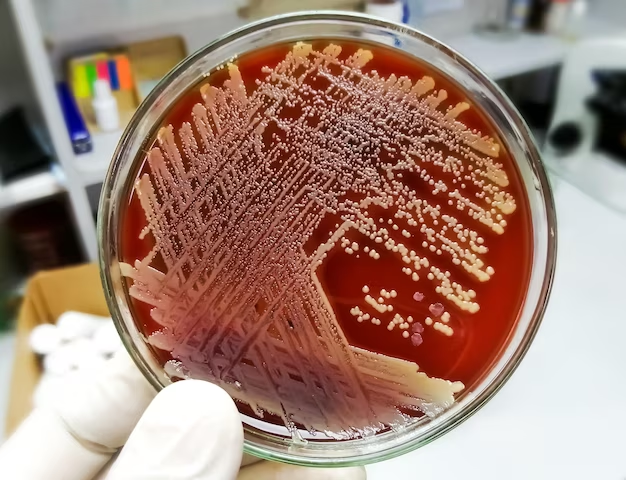

일본은 치명적인 박테리아 감염으로 인해 급속히 증가하는 위협에 직면해 있으며 사례가 놀라운 속도로 확산되고 있습니다. 폐렴을 일으키는 연쇄상구균 중 Streptococcus pneumonia 가 가장 일반적으로 알려져 있긴 합니다만 이번 연쇄상구균 독성 쇼크증후군(STSS)는 Streptococcus pyogenes이라는 화농연쇄상구균에 의해 발병합니다.

일본 전역에서 연쇄구균 감염 사례 급증
일본 국립 전염병 연구소의 최신 보고서에 따르면 연쇄구균 감염 사례가 크게 급증했습니다. 지난해 신고된 신고건수는 총 941건으로 올해 1~2월에만 378건이 접수되었습니다. 놀랍게도 이번 감염은 광역시와 2개 현을 제외한 일본 전역에서 확인되었습니다.
현재 긴장의 심각성
현재 박테리아 균주는 50세 미만 환자의 사망률이 더 높으며, 이는 노인의 일반적인 위험 그룹과 다릅니다. 이 젊은 층의 진단 사례 중 21명의 사망자가 기록되었습니다. 이러한 걱정스러운 추세는 2024년 연쇄구균 쇼크 증후군 사례가 이전의 모든 기록을 넘어설 가능성이 있음을 나타냅니다.
연쇄구균 감염 및 치료 이해하기
이러한 감염의 대부분을 차지하고 있는 박테리아인 화농성 연쇄상구균은 주로 어린이에게 인후염을 일으키는 것으로 알려져 있습니다. 그러나 전염성이 매우 높으며 모든 연령대의 개인에게 감기와 유사한 증상을 유발할 수 있습니다. 합병증의 위험은 높으며 사망률은 약 30%입니다.


효과적인 치료 전략
감염된 사람들에게는 즉각적이고 집중적인 치료가 중요합니다. 여기에는 일반적으로 감염의 특정 변종을 퇴치하기 위해 맞춤화된 항생제와 기타 약물의 조합이 포함됩니다.
결론
일본에서 연쇄구균 감염 사례의 급증은 특히 젊은 인구에게 더 심각한 영향을 미치는 변종의 출현으로 심각한 공중 보건 문제를 야기합니다. 즉각적인 의학적 개입과 함께 증상에 대한 인식과 이해가 이 치명적인 감염의 확산을 예방하는 데 중요합니다.
'우리 모두 건강하게' 카테고리의 다른 글
| 위고비의 효과 : 체중 감량을 넘어 심혈관 건강까지 (0) | 2024.06.20 |
|---|---|
| 니아신(Niacin)의 하루 적정량은? (0) | 2024.05.12 |
| 전립선 비대증 증상과 원인, 그리고 치료 (0) | 2023.12.15 |
| 전립선암 예방과 치료를 위한 실용적 조언 및 팁 (0) | 2023.12.15 |
| 빈대 예방과 치료 그리고 퇴치 - 빈대 曰 흡혈만 할 수 있다면 (0) | 2023.11.09 |
댓글